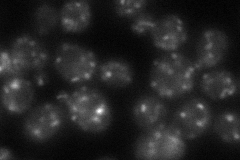
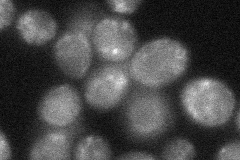
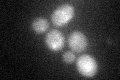

View description
Protein that interacts with Rab GTPases, localized to late Golgi vesicles; computational analysis of large-scale protein-protein interaction data suggests a possible role in vesicle-mediated transport
Localization:
Intensity:
Fold change:
Significance:
-
C’ GFP library in SD

cytosol21.24 -
N' NOP1pr-GFP in SD

punctate75.3148 -
N' TEF2pr-mCherry in SD

vacuole101.813 -
N' NATIVEpr-GFP in SD
punctate45.7818 -
N' TEF2pr-VC and Cyto-VN in SD
cell periphery,punctate31.3457 -
C’ GFP library in SD+DTT
cytosol20.260.95No -
C’ GFP library in SD+H2O2

cytosol17.670.83No -
C’ GFP library in Starvation Media

cytosol15.420.72No -
C’ GFP library on the background of Pup2-DaMP

cytosol -
C’ GFP library on the background of CCT mutant

cytosol21.45631.00968No
